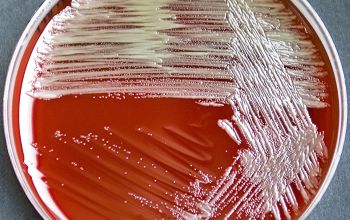
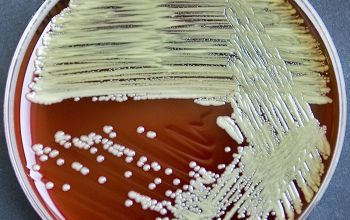
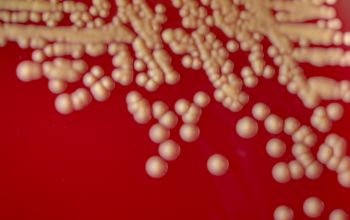
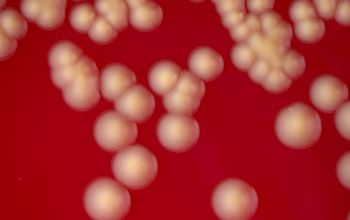
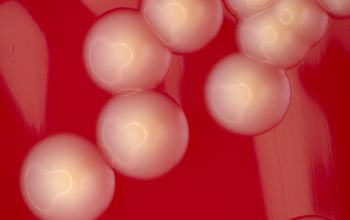
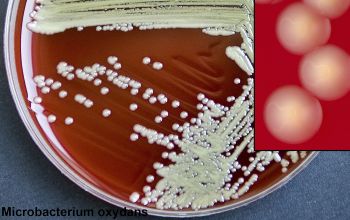

Microbacterium oxydans
-
General information
Microbacteria account for the majority of yellow-pigmented coryneform bacteria isolated from clinical samples
Taxonomy
Family:Microbacteriaceae
Natural habitats
Occur in the environment and in dairy products.
Clinical significance
Rarely causes an infection, but the infection can be serious.
Have been isolated from blood cultures, foreign-body infections, wound infections.
-
Gram stain
Gram positive irregular (short) rods,
lying single, in groups, or in irregular V-shape.
In older cultures the rods are shorter.
-
Culture characteristics
-
Obligate aerobic
BA: colonies have a yellow pigment, in various shades, from pale yellow to bright yellow, and orange.
McConkey: growth
BBAØ: no growth (sometimes weak)
-
-
Characteristics
-
References
James Versalovic et al.(2011) Manual of Clinical Microbiology 10th Edition
Karen C. Carrol et al (2019) Manual of Clinical Microbiology, 12th Edition